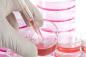

週間ランキング
- 期間:2013/07/01~07/07 カテゴリー総合
-
健康な成人男性1人をまるごと臓器闇市場に出すと総額いくらになるのか?
- 1494 points
-
ツングースカ大爆発の原因が解明される(国際研究)
- 455 points
-
巨人に食べられた気分を味わえる?進撃の巨人的人体空間を堪能できるオランダ「コルプス博物館」
- 454 points
-
2013年、世界の危険な都市トップ10
- 419 points
-
カニカマを使って進撃の巨人になる方法
- 317 points
-
待っていかないで!おねえさんの後を全力でついてくるかわいいアヒルの子
- 298 points
-
現代における10のカニバリズム
- 289 points
-
赤い目をした巨大なキリギリス「レッドアイ・デビル」がコオロギを捕食する映像(昆虫注意)
- 270 points
-
動物たちのかわいいしぐさをもりもり集めた31枚の画像
- 265 points
-
なにこれ超うらやましい。バイクと一緒に並んで走る(飛ぶ)タンデム走行の鳥の姿が!
- 172 points
-
恐怖ポイントが手に取るようにわかる。一人称視点で見る高所パルクール
- 153 points
-
カワウソの「いつもより多く回しております」
- 150 points
-
自己再生能力を携えたタイヤ、何本釘を踏んでもパンクしない。
- 149 points
-
食用じゃなくペット用、チリにある大規模タランチュラ養殖農場(昆虫注意)
- 148 points
-
ガイ・フォークスの仮面工場は大忙し。ブラジルの抗議デモの影響で
- 146 points
-
映画内の効果音はこうやって作られていた
- 139 points
-
第二次世界大戦に使用されたバンカーから発掘した弾丸の断面図
- 138 points
-
人気テレビドラマ「デクスター」の等身大の激リアルなケーキ。切り分けたらやばいことに。
- 134 points
-
iPS細胞を使い動物体内でヒトの臓器を作り出す研究を国家が容認(日本)
- 134 points
-
路上駐車許すまじ!駐車場で迷惑駐車をしている車に固い鉄拳を下す男性
- 119 points
-
飲むパスワード?貼るパスワード?パスワードの未来
- 114 points
-
白昼鳴り響く謎の怪音。中国北京市内で巨大な音が12分間に渡り鳴り響く
- 112 points
-
愛され上手なピンク色をした7つの生物+さらに新キャラ追加!
- 104 points
-
ペトリ皿の中の小宇宙、逆にアートから科学にアプローチをしかけてみた
- 101 points
-
どうなってるの?英ロンドンにオープンした無重力感覚を味わえる錯視の家
- 100 points
-
なんというハンドキャノン!轟々と噴きあがる火柱のシャワーを浴びながら花火を抱きかかえる日本伝統の「手筒花火」に世界が驚愕
- 91 points
-
金魚は音楽を区別できる。だが好みはないようだ(慶応大研究)
- 88 points
-
ある日森の中、オオカミに出合った羊の親子。この後どうなる??「実録:ノルウェーの森」
- 87 points
-
広島県の干潟でユムシの新種が発見される
- 85 points
-
猫語が話せるというおねえさんに対する4匹の猫の反応
- 82 points
-
全てが紙でできた都市、簡単に建つけど簡単に壊れちゃうところに刹那を感じるショートフィルム「Paper City」
- 77 points
-
植物も早回しで見ると、そこはかとなくエイリアン
- 72 points
-
明るい光とともに天使が舞い降り少女の命を救う?(米ノースカロライナ)
- 72 points
-
巨大魚「タマカイ」痛恨の一撃!狙った先は??
- 70 points
-
医療従事者の為の患者の疾患画像共有アプリ「figure1」
- 63 points
-
君はともだち♪っていったじゃないかぁあ!!ウッディが薄笑いで次々と殺戮を繰り返すアナザー・トイストーリー
- 63 points
-
よく見るといろいろ楽しい、複雑カオスな成長し過ぎた都市絵図
- 62 points
-
誰よりも速くルームランナーを駆け抜ける男、その走りっぷりがスゴスギス!
- 62 points
-
河川が赤や緑に染まる時、フルオレセインを使った河川調査
- 61 points
-
リスがおにいさんの手のひらまでダーイブ!!
- 57 points
-
見ているだけでお腹が一杯、世にある様々なものを3Dにしてピザ柄にしてGIFアニメにするプロジェクト
- 55 points
-
我々を幻想世界へいざなってくれる特殊撮影を施したサーカス映像「Near the Egress」
- 54 points
-
里親を探すため、米ニューヨークで開催された児童養護施設にいる子どもたちの写真展
- 50 points
-
やらかしグレイハウンド、PCデスクが気になってしょうがないんだもん。
- 50 points
-
ヤドカリの家探しの悲喜こもごもを描いたショートフィルム「ホームレス」
- 48 points
661/950